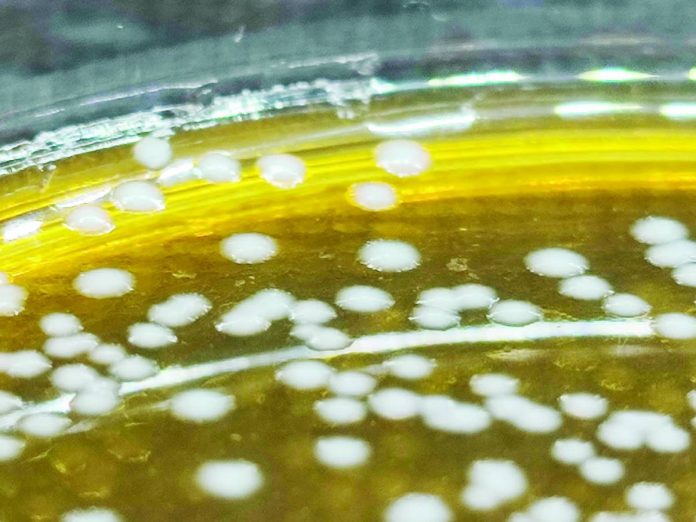

FILIPINO fermented foods have long been known to contain bacteria that offer health benefits, also known as probiotics. Burong isda, a traditional fermented fish from Pampanga, contains a bacterium called Limosilactobacillus fermentum (L. fermentum), which is closely related to the well-known Lactobacillus probiotics.
Researchers from UP Diliman College of Science (UPD-CS) combined genomic and laboratory analyses to provide a comprehensive probiotic profile of two L. fermentum strains in burong isda. Their multidimensional approach also revealed the strains’ antifungal benefits against Aspergillus fumigatus (A. fumigatus), one of the most common fungi affecting immunodeficient individuals. Their study not only lays the groundwork for developing new probiotic products but is also possibly the first to report the antifungal effects of L. fermentum against A. fumigatus.
“Historically, probiotic research in the Philippines has relied heavily on culture-based methods and basic molecular techniques,” said corresponding author Joshua Veluz from UPD-CS National Sciences Research Institute (NSRI). “This work underscores the value of combining genomics, metabolomics, and assays as a powerful and timely approach to uncovering the full probiotic potential of microbes found in Philippine fermented foods.”
Veluz, a Kapampangan, said that he has a keen interest in this research because he grew up eating burong isda. He became curious about its potential after learning that Filipino fermented foods also have health benefits aside from their cultural significance. This curiosity led him to begin working on the study in 2019. “This personal and academic connection made the study deeply meaningful to me,” he said.
Along with Veluz, the study authors are Paul Christian Gloria and Dr. Maria Auxilia Siringan of UPD-CS NSRI, along with Dr. Irineo Dogma Jr. of the University of Santo Tomas (UST).
A key characteristic of probiotics is their ability to survive the harsh conditions of the digestive system. They discovered that while these strains may struggle to grow in highly acidic environments like the stomach, they had no difficulty growing in less acidic conditions, as in most parts of the gastrointestinal tract.
Furthermore, the researchers discovered that the strains carry several genes known to help boost the host’s immune system, along with genes related to producing essential vitamins such as B1, B2, B6, and B9. The strains were also found to be non-pathogenic and have a very low potential to transfer antimicrobial resistance genes.
“Additionally, the strains produce compounds that inhibit the growth of certain fungi known to cause infections,” said Veluz. Previous studies have shown that L. fermentum possesses antifungal effects against different fungi, but this study may be the first to demonstrate its potential against A. fumigatus. This suggests that L. fermentum could serve as a broad antifungal product, including against A. fumigatus.
The researchers are now exploring additional probiotic properties of the strains and assessing their stability to ensure they can be safely used for future health applications.
“We aim to further characterize their functional traits and contribute to the growing field of probiotic research in the Philippines, especially using OMICs,” concluded Veluz. (Harvey Sapigao, UPD-CS Science Communications)